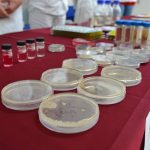

Povodom 20. godine djelovanja proteklog tjedna održan je Dan otvorenih vrata Zavoda za javno zdravstvo naše županije. Svaki zainteresirani građanin mogao je doći izmjeriti šećer, tlak, razinu kolesterola, educirati se o radu Zavoda ali i postaviti pitanja za sve što ih zanima.
Kako je kvaliteta vode za piće čest problem u Dubrovniku, raspitali smo se – i saznali smo – na koji način Zavod odrađuje analize vode te kako građani mogu sudjelovati u tom procesu.
Detalje potražite u tiskanom izdanju DuLista.